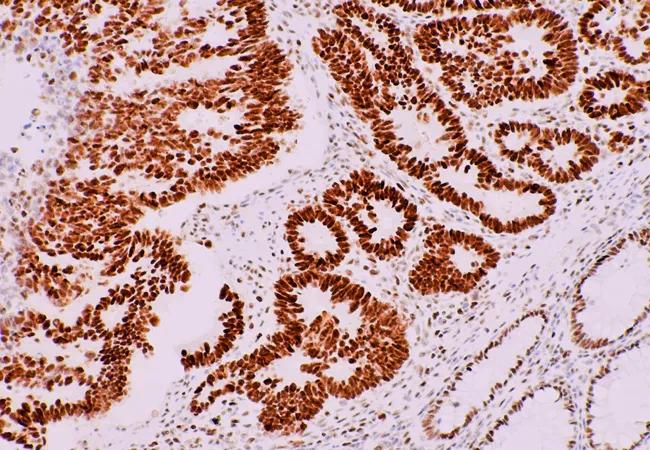

Study sheds light on value of genetic testing
Image content: This image is available to view online.
View image online (https://assets.clevelandclinic.org/transform/232e340e-a955-4aa4-9dd9-b979d6370c79/Colon-cancer_650x450_jpg)
Colon-cancer_650x450
By Caitlin Carr, MD; Milena Radeva; Anju Priyadarshini, MD; Jessica Marquard MS,LGC ; and Mariam Alhilli, MD
Advertisement
Cleveland Clinic is a non-profit academic medical center. Advertising on our site helps support our mission. We do not endorse non-Cleveland Clinic products or services. Policy
Lynch syndrome (LS) is a highly penetrant, autosomal dominant inherited cancer condition responsible for the majority of hereditary endometrial and colorectal cancers. This condition is caused by inherited mutations in the four mismatch repair (MMR) genes MLH1, MSH2, MSH6 and PMS2, ultimately leading to DNA microsatellite instability (MSI).
Although colorectal cancer (CRC) is the most common malignancy overall in LS, endometrial cancer (EC) is the first malignancy diagnosed in approximately 50 percent of women with LS. Germline defects in DNA MMR have been reported in up to 9 percent of endometrial EC patients under age 50, denoting early development of EC versus the general population.
Studies have shown a median of 11 years between the diagnosis of EC and CRC in LS patients. This confers a diagnostic advantage, allowing for intervention with appropriate risk-reduction strategies to decrease subsequent LS malignancies, family planning or reproductive assistance, and testing of family members who may be at risk.
While traditional LS screening criteria (such as the Bethesda guidelines) miss 12 to 30 percent of LS-associated ECs, immunohistochemistry (IHC) testing of endometrial cancer specimens to detect absence in staining of any of the four MMR proteins has a sensitivity of 94 to100 percent and can be used in conjunction with MSI testing to identify patients who have tumor mutations suggestive of LS. Such patients can be referred to a genetic counselor for further germline testing for definitive diagnosis of LS.
Advertisement
Initiated in 2009, universal screening using MSI and/or IHC for LS in colorectal cancer is now widely established in the United States, and is currently a CDC Tier 1 genomic application.
The acceptance of universal tumor testing in endometrial cancer has been much slower to progress. Though the Society of Gynecologic Oncology now recommends molecular screening of EC for LS as the preferred strategy, its adoption has not been widespread.
At our institution, implementation of universal screening for EC, initiated in 2012, has allowed for characterization of LS patients in what is to our knowledge one of the largest prospective cohorts of screened patients. This database provides fertile ground for generalizability and further information regarding the relationship between MMR classification and clinicopathologic characteristics suggestive of LS.
We wanted to assess the value of universal screening for Lynch syndrome in patients with EC due to the importance of furthering understanding of detection and prevention for this syndrome. In addition, the large database of IHC results constructed by the Genomic Medicine Institute provides the potential for prospective analysis that has been achieved by a very small number of institutions thus far.
We utilized data from the Cleveland Clinic prospective universal screening database of all patients with the pathologic diagnosis of endometrial cancer (mentioned above). A total of 723 patients underwent tumor testing with IHC analysis to identify defects in MMR proteins. Patients with intact MMR expressed were considered to have sporadic EC. Those with absent MMR proteins and negative for MLH1 methylation (n=33) were considered Lynch syndrome suggestive, and were offered genetic counseling and germline testing for definitive diagnosis of LS.
Advertisement
On multivariable analysis utilizing Lynch-suggestive tumors as the reference characteristic, we found that those patients suggestive of Lynch syndrome were of younger age (P = 0.0008) and had a lower BMI (P = 0.0017) than MMR intact patients. Lynch-suggestive tumors were also higher grade (P = <0.0001), of endometrioid histology (P = 0.0021), < 2 cm in size (P = 0.013), and were more likely to have greater than 50 percent invasion into the myometrium (P = 0.037).
Interestingly, family history of first degree or second degree Lynch-associated tumors, positive lymphovascular space invasion (LVSI), International Federation of Gynecology and Obstetrics (FIGO) stage, race, parity and menopausal status were not associated with suggestive LS. The association of substantial myometrial invasion and higher histological grading has been highly associated with poorer prognostic features; however, we found no difference in overall survival (OS) or recurrence-free survival (RFS) between those suggestive of LS and those patients with MMR-intact tumors.
When comparing sporadic ECs with intact MMR versus sporadic EC with MLH1 hypermethylation, we found that older age (P = 0.002), endometrioid histology (P = 0.09), and tumor size < 2 cm were independently associated with EC due to MLH1 hypermethylation (P = 0.004). There was a statistically significant increase in the rate of recurrence and a decrease in RFS in those patients with sporadic ECs due to MLH1 methylation, with a median time to recurrence in the MLH1 cohort at 17.5 months versus 22.7 months for the MMR-intact cohort. There was no significant difference in OS between these groups.
Advertisement
Our findings add to the growing body of literature regarding the presence of definitive clinical and pathological characteristics associated with MMR defects suspicious for LS. These findings are in line with previous work demonstrating that LS is associated with younger age, lower BMI, higher grade and myometrial invasion.
We also found that age-based screening protocols would have overlooked 30.8 percent of confirmed LS patients if these protocols maintained 60 as their age limit. In addition, the revised Bethesda criteria included only one of the Lynch-suspicious patients and none of those with germline diagnosis, reinforcing the need for universal screening for LS in EC patients.
ECs with MLH1 hypermethylation are associated with known adverse prognostic factors, including older age, higher grade, LVSI, and myometrial invasion > 50 percent. These tumors have a higher rate of recurrence overall (including those with early stage disease) and a significantly lower RFS versus sporadic EC, raising an important question regarding the possible utilization of universal IHC tumor testing for purposes outside of Lynch syndrome detection.
MLH1 methylated status appears to be an important prognostic factor to consider in patient counseling and treatment decision-making in endometrial cancer.
Dr. Carr is a fourth-year Ob/Gyn resident, Milena Radeva is a statistician in the Department of Quantitative Health Sciences, Dr. Priyadarshini is research assistant in the Ob/Gyn & Women’s Health Institute, and Jessica Marquard is genetic counselor in the Genomic Medicine Institute.
Advertisement
Advertisement
First-of-its-kind research investigates the viability of standard screening to reduce the burden of late-stage cancer diagnoses
Global R&D efforts expanding first-line and relapse therapy options for patients
Study demonstrates ability to reduce patients’ reliance on phlebotomies to stabilize hematocrit levels
A case study on the value of access to novel therapies through clinical trials
Findings highlight an association between obesity and an increased incidence of moderate-severe disease
Cleveland Clinic Cancer Institute takes multi-faceted approach to increasing clinical trial access 23456
Key learnings from DESTINY trials
Overall survival in patients treated since 2008 is nearly 20% higher than in earlier patients